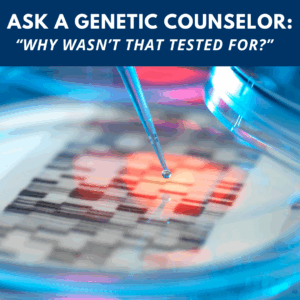
Ask a Genetic Counselor: “Why wasn’t that tested for?”

January Is Cervical Cancer Awareness Month: Why HPV Screening Matters in Sperm Donation
January is Cervical Cancer Awareness Month, a time dedicated to education, prevention, and early detection ...

6 Questions to Ask Yourself Before Pursuing Donor Conception in 2026
Pursuing Donor Conception in 2026 Choosing donor conception is a deeply personal decision, one that ...

The Gift I Gave Myself: Choosing to Become a Single Mom by Choice
by Candice Katherine Febrile The holidays do something to us, don’t they? They bring out ...

PatientFi & Fairfax Cryobank: Make Family Building More Accessible with 12-Month Zero-Interest Financing
At Fairfax Cryobank, we know that creating your family is one of life’s most meaningful ...

Male Factor Infertility: Top Causes and How Donor Sperm Can Help
When most people hear “infertility,” they tend to think about female reproductive health. But here’s ...

Your Path Forward: PCOS, Infertility, and Donor Sperm Options
Polycystic Ovary Syndrome (PCOS) is one of the most common hormonal disorders affecting individuals of ...

Donor Spotlight: Meet Our Culinary Donors
Food has a way of bringing people together, and our culinary donors know that better ...
Ask a Genetic Counselor: “Why wasn’t that tested for?”
by Shannon Weiloch, Fairfax Cryobank Genetic Counselor One of the most common questions we hear ...

Why U.S. Fertility Rates Are at a Historic Low and What That Means for Family Building
In 2024, the U.S. fertility rate dropped to an all-time low of 1.599 children per ...

Donor Spotlight – Meet our Musical Sperm Donors
At Fairfax Cryobank, our donors come from all walks of life and some carry a ...







